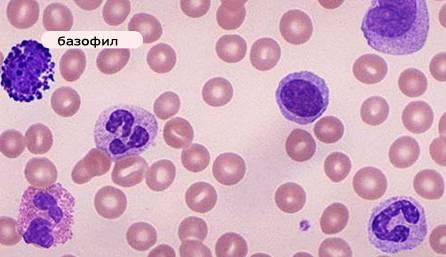
bazofily-v-krovi.png

О чем может говорить повышенный уровень базофилов в крови у взрослого человека
Этиология
Базофилы – это элементы лейкоцитов. Причины того, что базофилы выше нормы, могут быть следующими:
- заболевания кроветворной системы;
- различные виды анемии;
- онкологические заболевания;
- патологические процессы в костном мозге;
- аллергические реакции;
- инфекционные заболевания;
- болезнь Ходжкина (лимфогранулематоз);
- гастроэнтерологические заболевания;
- острый дефицит железа.
Кроме этого, выделяют физиологические причины того, что базофилы в крови повышены:
- постоперационный период после удаления селезенки;
- прием гормональных препаратов;
- период выздоровления после затяжного инфекционного или воспалительного заболевания;
- время перед началом менструации у женщин.
Установить точно, почему базофилы повышены у взрослого, может только врач – нельзя самостоятельно сопоставлять имеющиеся симптомы с заболеванием и проводить на основании этого лечебные мероприятия.
Базофилы в крови
Причины повышения выше нормы
Причинами повышение базофилов являются:
- Аллергические реакции,
- Инфекционные заболевания печени в острой форме,
- Воспалительные процессы в области ЖКТ (желудочно-кишечного тракта),
- ПМС (предменструальный синдром у женщин),
- Болезни кровеносной и кроветворной систем,
- Превышения излучения радиации.
Оценка уровня базофилов совершается на основе общего анализа крови, сделанного утром натощак. Своевременная диагностика позволяет определить заболевания до начала проявления патологии.
Причины повышения у взрослых
Повышенная выработка базофилов всегда имеет свою причину.
Нередко к данной патологии приводит:
- Стрессовые ситуации,
- Респираторные заболевания,
- Онкология (карцинома, лимфома, новообразования в области костного мозга),
- Аллергическая реакция,
- Воспалительные процессы (экзема, ревматоидный артрит, колит, болезнь Крона),
- Грипп, туберкулез,
- Анемия, общее истощение.
Причины повышения у ребенка
Повышение уровня базофилов в крови у детей свидетельствует о мощной защитной реакции организма.
Таким раздражителем может быть:
- Пищевое отравление,
- Гельминтная инвазия,
- Укус насекомого,
- Аллергия,
- Проблемы с щитовидкой,
- Инфекции,
- Анемия или лейкоз,
- Расстройстве желудочно-кишечного тракта.
Точную причину развитию патологии может установить только специалист на основе комплексного исследования.
Что такое базофилы в анализе крови?
Базофилы – это субпопуляция белых кровяных клеток. Отличительная особенность – это способность ядра поглощать основный краситель. Данная способность позволяет легко дифференцировать базофилы от других клеток в крови.
Напомним, что эозинофильные гранулоциты окрашиваются в интенсивно розовый цвет, а нейтрофилы поглощают кислые и основные красители.
В виду большого содержания гранул гистамина, лейкотриенов, простагландинов и других медиаторов аллергических реакций, ядро в цитоплазме практически не различимо. Размеры клеток в сравнительном аспекте значительно превышают представителей других субпопуляций лейкоцитов: нейтрофилов и эозинофилов.
Зачем нужны базофилы?
Первоначально считалось, что базофилы выступают в роли предшественников тучных клеток в крови. Основанием для данного утверждения послужила их морфологическая и функциональная схожесть. Оба типа клеток содержат в цитоплазме гранулы и медиаторы аллергии. А при контакте с иммуноглобулинами класса Е – высвобождают гистамин.
Однако детальное изучение клеток опровергло данное предположение. Установили, что базофилы поступают в кровь из костного мозга уже созревшими.При этом тучные клетки дозревают в системном кровотоке человека и только после этого проникают в клетки тканей. Справедливо утверждать лишь о родстве двух этих двух видов клеток.
Основная роль базофилов: участие в развитии аллергической реакции – анафилаксии. Она возникает на фоне повторного контакта человека с веществом, к которому он проявляет индивидуальную непереносимость. Частота встречаемости летальных исходов достигает 20 %. В этом случае базофилы в крови повышены до критических значений.
Механизм защитной реакции основан на способности к быстрому разрушению базофильных гранулоцитов и высвобождению их клеточного содержимого. При контакте с комплексом «антиген-антитело» также происходит растворение клеток.
В кровь поступают в большом количестве медиаторы аллергической реакции, которые запускают типичный иммунный ответ. Защитный механизм позволяет блокировать распространение токсинов по органам и тканям в организме человека. В место локализации происходит естественный приток жидкостей с различными видами лейкоцитов.
Еще одна особенность – способность к проникновению через стенки кровеносных сосудов за их пределы и дальнейшее существование в тканях органов. В этом случае базофилы становятся полноценными тканевыми тучными клетками.
Имеются сведения об их фагоцитарной активности и способности перемещения при воздействии химического раздражителя. Однако в естественных условиях реализация данной функции сведена к минимуму.
Частые вопросы
Что может означать повышенный уровень базофилов в крови у взрослого человека?
Повышенный уровень базофилов в крови у взрослого человека может указывать на аллергическую реакцию, а также на наличие воспалительных или иммунных реакций в организме.
Какие заболевания могут быть связаны с повышенным уровнем базофилов в крови?
Повышенный уровень базофилов в крови может быть связан с аллергическими заболеваниями, хроническими воспалительными заболеваниями, а также с некоторыми гематологическими заболеваниями, такими как хронический миелоидный лейкоз.
Какие дополнительные исследования могут быть назначены при выявлении повышенного уровня базофилов в крови?
При выявлении повышенного уровня базофилов в крови могут быть назначены дополнительные исследования, такие как анализы на аллергены, общий анализ мочи и кала, а также биохимические анализы для выявления возможных воспалительных процессов в организме.
Полезные советы
СОВЕТ №1
Обратитесь к врачу для проведения дополнительных обследований и уточнения причин повышенного уровня базофилов в крови.
СОВЕТ №2
Избегайте самолечения и приема медикаментов без назначения врача, так как это может ухудшить состояние.
СОВЕТ №3
Поддерживайте здоровый образ жизни, включая правильное питание, физическую активность и отказ от вредных привычек, чтобы укрепить иммунную систему.

Какие нормы базофилов в крови
Какие нормы базофилов в крови Что делать при повышении уровня базофилов и что это может означать?
Что делать при повышении уровня базофилов и что это может означать? Базофилы повышены у ребенка
Базофилы повышены у ребенка


 Базофилы повышены у взрослого — о чем это говорит
Базофилы повышены у взрослого — о чем это говорит Повышенный уровень лейкоцитов в крови ребенка: причины лейкоцитоза, последствия и лечение
Повышенный уровень лейкоцитов в крови ребенка: причины лейкоцитоза, последствия и лечение Повышенный уровень лимфоцитов в крови
Повышенный уровень лимфоцитов в крови Норма глюкозы в крови, повышенный уровень сахара в крови
Норма глюкозы в крови, повышенный уровень сахара в крови